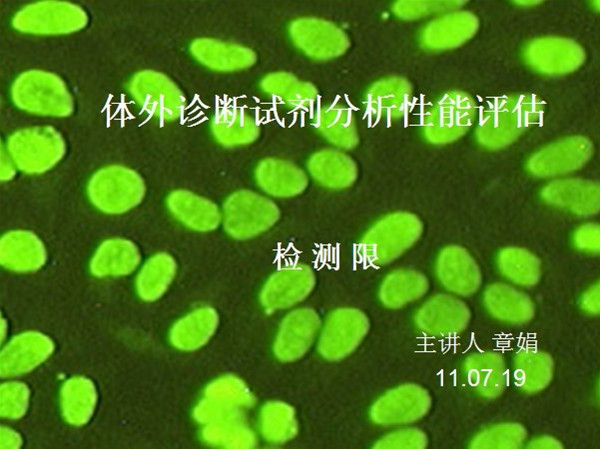

華美新聞

重組蛋白研發(fā)中心學(xué)術(shù)會(huì)議:克隆載體改造技術(shù)
2011年8月3號(hào)重組蛋白研發(fā)中心進(jìn)行了第四次內(nèi)部學(xué)術(shù)會(huì)議,這次主講人為蛋白組張健和克隆組的陳立。張健就原核基因的表達(dá)調(diào)控模式特別是乳糖操縱子模式進(jìn)行了詳細(xì)講解。陳立則立足于載體,介紹了克隆載體...
查看詳情
2011年8月5日,我公司研發(fā)部在總經(jīng)理華權(quán)高和技術(shù)總監(jiān)沈鶴霄的參與下于研發(fā)部的綜合實(shí)驗(yàn)室舉行了2011年研發(fā)部第一批新員工的入職會(huì)議。 入職會(huì)議——不斷壯大的研發(fā)團(tuán)體 首先華權(quán)高總經(jīng)理...
查看詳情
RT-PCR研發(fā)中心學(xué)術(shù)會(huì)議:目的基因的制備
2011年8月2日,RT-PCR研發(fā)中心進(jìn)行了第四次組內(nèi)學(xué)術(shù)會(huì)議,會(huì)議的主講人是王營(yíng)。本次會(huì)議的主要講述了目的基因的制備流程:從真核生物的組織或細(xì)胞中提取mRNA,通過(guò)酶促反應(yīng)逆轉(zhuǎn)錄合成cDNA第一鏈,最后經(jīng)P...
查看詳情
重組蛋白研發(fā)中心學(xué)術(shù)會(huì)議:基因工程的理論基礎(chǔ)和應(yīng)用
2011年7月1日,重組蛋白組進(jìn)行了第三次學(xué)術(shù)會(huì)議。魏光就基因工程的理論基礎(chǔ)和應(yīng)用做了一個(gè)總體的介紹。主要講述了在基因工程中的三個(gè)工具:一、“剪刀”即限制性內(nèi)切酶;二、“針線”即連接酶;三、裝載目的基因
查看詳情
重組蛋白研發(fā)中心學(xué)術(shù)會(huì)議:含GST標(biāo)簽可溶性蛋白的提取和純化
2011年6月3日,重組蛋白組進(jìn)行了第二次學(xué)術(shù)會(huì)議,張振為大家講解了含GST標(biāo)簽可溶性蛋白的提取和純化過(guò)程。蛋白純化一般有三個(gè)大的階段:1 搖菌;2 誘導(dǎo);3 提取。在純化過(guò)程中,他提到了幾個(gè)特別需要注意的點(diǎn):1
查看詳情
天然蛋白研發(fā)中心學(xué)術(shù)會(huì)議:抗體的純化
2011年7月1日 天然蛋白研發(fā)中心進(jìn)行了第三次組內(nèi)學(xué)術(shù)會(huì)議,本次主講人李旭。結(jié)合工作實(shí)際,詳細(xì)介紹了各種多抗單抗的純化方法、原理、操作注意事項(xiàng),并對(duì)各種純化方法的優(yōu)缺點(diǎn)進(jìn)行了深入對(duì)比。
查看詳情
天然蛋白研發(fā)中心學(xué)術(shù)會(huì)議:蛋白純化方法簡(jiǎn)介
2011年5月6日 天然蛋白研發(fā)中心進(jìn)行了第一次組內(nèi)學(xué)術(shù)會(huì)議,本次會(huì)議主講人馬峰,主要介紹了親和層析、離子交換層析、疏水作用層析、凝膠過(guò)濾、超濾等蛋白純化常見(jiàn)方法及其相關(guān)設(shè)備。對(duì)各種純化方法的特點(diǎn)、原理...
查看詳情
天然蛋白研發(fā)中心學(xué)術(shù)會(huì)議:凝膠層析法分離純化蛋白質(zhì)
2011年6月10日 天然蛋白研發(fā)中心進(jìn)行了第二次組內(nèi)學(xué)術(shù)會(huì)議,本次會(huì)議主講人廖怡輝,深入介紹了凝膠過(guò)濾層析的原理、操作細(xì)節(jié)。從原理到凝膠的選擇,處理,裝柱,平衡,上樣,洗脫,收集檢測(cè)到層析柱的處理的每一...
查看詳情
酶免試劑盒研發(fā)中心學(xué)術(shù)會(huì)議:體外診斷試劑分析性能評(píng)估2
2011年7月19日,酶免試劑盒研發(fā)中心進(jìn)行了第三次組內(nèi)學(xué)術(shù)會(huì)議,這次學(xué)術(shù)會(huì)議主講人為章娟,主要對(duì)ELISA試劑盒的檢測(cè)限的評(píng)估方法及評(píng)估意義做了簡(jiǎn)單的闡述。以三聚氰胺快速檢測(cè)試劑盒為例,從樣本的處理,樣本檢...
查看詳情
酶免試劑盒研發(fā)中心學(xué)術(shù)會(huì)議:酶聯(lián)免疫吸附試驗(yàn)
2011年5月17日,酶免試劑盒研發(fā)中心進(jìn)行了第一次組內(nèi)學(xué)術(shù)會(huì)議,這次學(xué)術(shù)會(huì)議主講人為王政,會(huì)議主要對(duì)酶聯(lián)免疫吸附實(shí)驗(yàn)(ELISA)的定義、實(shí)驗(yàn)原理以及檢測(cè)方法等分別做了簡(jiǎn)單的闡述。通過(guò)對(duì)ELISA的定義、實(shí)驗(yàn)原理...
查看詳情
小分子研發(fā)中心學(xué)術(shù)會(huì)議:半抗原與完全抗原的鑒定方法
2011年7月8日,小分子研發(fā)中心進(jìn)行了第三次組內(nèi)學(xué)術(shù)會(huì)議,這次學(xué)術(shù)會(huì)議主講人姜莎,主要就半抗原與完全抗原的鑒定方法進(jìn)行介紹,包括紫外分光光度法、紅外分光光度法、質(zhì)譜法、核磁共振、ELISA法等,并就這些方法...
查看詳情
重組蛋白研發(fā)中心學(xué)術(shù)會(huì)議:包涵體蛋白的純化
2011年5月5日,重組蛋白研發(fā)中心進(jìn)行了第一次組內(nèi)學(xué)術(shù)會(huì)議,會(huì)議主要對(duì)包涵體的定義及特征、包涵體形成的原因、包涵體分離的工藝路線等進(jìn)行了闡述。主要對(duì)影響包涵體純化的各個(gè)因素進(jìn)行了分析,并且給出了優(yōu)化的...
查看詳情
單抗技術(shù)研發(fā)中心學(xué)術(shù)會(huì)議:?jiǎn)慰寺】贵w的制備
2011年5月13日,單抗研發(fā)中心進(jìn)行了第一次組內(nèi)學(xué)術(shù)會(huì)議,這次學(xué)術(shù)會(huì)議主講人陳瑩,主要對(duì)單克隆抗體的基本技術(shù)流程和具體操作的注意事項(xiàng)進(jìn)行了講述。基本技術(shù)流程方面主要針對(duì)免疫技術(shù)、雜交瘤技術(shù)、雜交瘤...
查看詳情
單抗研發(fā)中心學(xué)術(shù)會(huì)議:小分子藥物單抗的篩選及細(xì)胞培養(yǎng)常見(jiàn)污染現(xiàn)象
2011年6月16日,單抗研發(fā)中心進(jìn)行了第二次組內(nèi)學(xué)術(shù)會(huì)議,這次學(xué)術(shù)會(huì)議主講人閆彩霞,主要針對(duì)小分子藥物單克隆抗體的制備、小分子藥物單克隆抗體的篩選過(guò)程及遇到的問(wèn)題等進(jìn)行了詳細(xì)的介紹;同時(shí)針對(duì)細(xì)胞培養(yǎng)過(guò)程...
查看詳情
RT-PCR研發(fā)中心學(xué)術(shù)會(huì)議:多克隆抗體的制備
2011年7月1日RT-PCR研發(fā)中心進(jìn)行了第三次組內(nèi)學(xué)術(shù)會(huì)議,這次會(huì)議主講人葉大勇。本次會(huì)議主要對(duì)多克隆抗體的制備原理及技術(shù)發(fā)展進(jìn)行了介紹,對(duì)多抗與單抗進(jìn)行了簡(jiǎn)單區(qū)分,對(duì)多抗的制備流程與注意事項(xiàng)進(jìn)行了詳細(xì)的...
查看詳情
小分子研發(fā)中心學(xué)術(shù)會(huì)議:小分子抗原設(shè)計(jì)
2011年5月13日,小分子研發(fā)中心進(jìn)行了第一次組內(nèi)學(xué)術(shù)會(huì)議,這次學(xué)術(shù)會(huì)議主講人閆彩霞,本次會(huì)議主要就小分子(半抗原)免疫分析方法的研究對(duì)象、優(yōu)勢(shì);半抗原選擇、人工抗原的結(jié)構(gòu)組成及設(shè)計(jì)的基本原則;人工抗原...
查看詳情
酶免試劑盒研發(fā)中心學(xué)術(shù)會(huì)議:體外診斷試劑分析性能評(píng)估1
2011年6月18日,酶免試劑盒研發(fā)中心進(jìn)行了第二次組內(nèi)學(xué)術(shù)會(huì)議,這次學(xué)術(shù)會(huì)議主講人劉丕菊。疾病的治療,診斷是第一步,而體外診斷試劑是重要的輔助手段。隨著新技術(shù)的發(fā)展和新疾病靶標(biāo)的發(fā)現(xiàn),開(kāi)發(fā)新型的體外診斷...
查看詳情
單抗研發(fā)中心學(xué)術(shù)會(huì)議:兔單抗及人源化抗體
2011年7月18日,單抗研發(fā)中心進(jìn)行了第三次組內(nèi)學(xué)術(shù)會(huì)議,這次學(xué)術(shù)會(huì)議主講人余焜,主要對(duì)兔單抗的優(yōu)點(diǎn)及單抗的人源化做了簡(jiǎn)單的描述。兔單抗部分主要講述了兔單抗與鼠單抗特異性的區(qū)別,也對(duì)兔與小鼠對(duì)某些小分子...
查看詳情
RT-PCR研發(fā)中心學(xué)術(shù)會(huì)議:參與PCR的成分及作用
2011年6月3日RT-PCR研發(fā)中心進(jìn)行了第二次組內(nèi)學(xué)術(shù)會(huì)議,這次會(huì)議主講人黃浩。本次會(huì)議主要對(duì)參與PCR反應(yīng)的成分做了一個(gè)簡(jiǎn)單的描述(主要包括:模板核酸、引物、DNA聚合酶、緩沖液、Mg2+、dNTP以及PCR促進(jìn)劑等),...
查看詳情
小分子研發(fā)中心學(xué)術(shù)會(huì)議:重氮化和偶合反應(yīng)
2011年6月28日小分子研發(fā)中心進(jìn)行了第二次組內(nèi)學(xué)術(shù)會(huì)議。這次學(xué)術(shù)會(huì)議主講人羅長(zhǎng)義,會(huì)議主要講述了在半抗原偶聯(lián)載體蛋白中的一種常見(jiàn)的方法——重氮化法。重點(diǎn)就重氮化反應(yīng)的條件及注意事項(xiàng)進(jìn)行了討論,并就重氮...
查看詳情
RT-PCR研發(fā)中心學(xué)術(shù)會(huì)議:逆轉(zhuǎn)錄PCR
2011年5月5日RT-PCR研發(fā)中心進(jìn)行了第一次組內(nèi)學(xué)術(shù)會(huì)議,這次會(huì)議主講人易汪雪,主要從RT-PCR的基本概念,主要實(shí)驗(yàn)步驟及注意事項(xiàng),實(shí)驗(yàn)中出現(xiàn)的常見(jiàn)問(wèn)題及如何分析三個(gè)方面進(jìn)行了講述。基本概念部分主要從RT和PCR...
查看詳情
為了加強(qiáng)在職員工的消防安全意識(shí),提高面對(duì)突發(fā)火災(zāi)時(shí)的應(yīng)變能力,防范杜絕消防安全事故,2011年7月武漢華美的領(lǐng)導(dǎo)組織了一次覆蓋公司各個(gè)部門的消防安全知識(shí)講座。進(jìn)行這次培訓(xùn)的是有著極強(qiáng)的專業(yè)理論知識(shí)和豐富...
查看詳情
我公司在湖北大學(xué)設(shè)立“武漢華美生物獎(jiǎng)助基金”
繼6月與湖北大學(xué)相關(guān)校領(lǐng)導(dǎo)和院領(lǐng)導(dǎo)進(jìn)行會(huì)談并達(dá)成初步合作意向后,7月4日在湖北大學(xué)大學(xué)生活動(dòng)中心我公司與湖北大學(xué)正式簽訂了相關(guān)協(xié)議,在湖北大學(xué)設(shè)立“武漢華美生物獎(jiǎng)助基金”。此基金將用于對(duì)湖北大學(xué)生命科...
查看詳情
我公司與湖北大學(xué)生命科學(xué)學(xué)院進(jìn)行科研合作會(huì)談
7月4日下午,公司總經(jīng)理華權(quán)高,副總蘇烈紅,技術(shù)總監(jiān)沈鶴霄受邀到湖北大學(xué)生命科學(xué)學(xué)院進(jìn)行合作會(huì)談,生科院對(duì)我公司的到來(lái)表示了熱烈的歡迎。陳建院長(zhǎng)、翟細(xì)春書(shū)記、吳文華副院長(zhǎng)及部分優(yōu)秀教師代表參...
查看詳情










